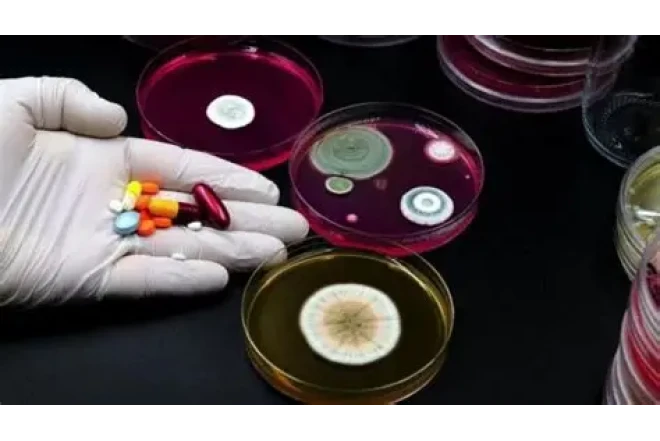
Çirkab suları dərmana davamlı bakteriyaların yayılması üçün mənbə ola bilir

Çirkab suları dərmana davamlı bakteriyaların yayılması üçün mənbə ola bilir
ÜST müntəzəm olaraq dərmana davamlı bakteriyaların əczaçılıq sənayesinin
yeni dərmanlar hazırlaya biləcəyindən daha sürətli yayıldığı barədə xəbərdarlıq
edir. Bu fonda çirkab suları problemi ilə bağlı tədqiqatlar xüsusilə vacib hala
gəlir.
News365.az xəbər verir ki, bakteriyalar həmişə
antibiotiklərə müqavimət göstərə biliblər - bu, onların təkamülünün bir hissəsidir.
Lakin insan fəaliyyəti bu prosesi sürətləndirib: dərmanlar həddindən
artıq istifadə olunur və ətraf mühitin çirklənməsi (məsələn, çirkab suları)
daha davamlı formaların seçilməsi üçün ideal şərait yaradır. Danimarka Texniki
Universitetinin tədqiqatçılarının rəhbərlik etdiyi beynəlxalq alimlər qrupu 111
ölkədən 1240 çirkab su nümunəsini antibiotikə davamlılıqla əlaqəli genlərin
mövcudluğuna görə təhlil edib. Adətən, monitorinq yalnız "aktiv" genləri,
daha sadə desək, bakteriyalar arasında artıq ötürülə bilən və infeksiyanı davamlı
edənləri axtarır. Lakin bu tədqiqat təbiətdə hələ özünü göstərməmiş, lakin
laboratoriyada bakteriyaları davamlı edə bilən gizli gen variantlarına yönəlib.
Məlum olur ki, bu "yatmış" gen variantları coğrafi
baxımdan məlum təhlükəli variantlardan daha geniş yayılmışdır. Alimlər təhlükələri
reallaşmadan əvvəl müəyyən etmək üçün bu cür gizli genləri müntəzəm monitorinqə
daxil etməyi təklif edirlər. Bu, yeni variantların harada və niyə ortaya
çıxdığını, nəticədə aktivləşə və patogen bakteriyalar arasında yayıla biləcəyini
anlamağımıza kömək edəcək.
News365.az
